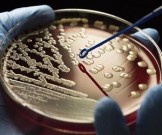

Новости здоровья

Первые январские недели всегда заставляют нас пересматривать повседневные привычки — особенно те, что помогают держаться в тонусе, несмотря на отсутствие света, холод в квартирах и общее напряжение, которое ощущают жители Украины.

В жизни человека алкоголь часто воспринимается как часть отдыха и общения. Но для некоторых людей даже небольшое количество спиртного становится испытанием: тело реагирует не расслаблением, а целым комплексом неприятных ощущений. Это не каприз организма, а сигнал о возможной непереносимости алкоголя.

Часто наиболее доступные и незатейливые привычки оказываются наиболее полезными. Одна из таких — утренний стакан тёплой воды: несложно, недорого и безопасно для большинства людей. Этот небольшой ритуал может стать стартовой точкой заботы о здоровье, который легко встроить в повседневный распорядок.

Зрение — один из самых тонких и чувствительных инструментов нашего тела. Мы редко задумываемся о его уязвимости, пока не начинаем щуриться от света, ощущать сухость или замечать лёгкое затуманивание.
Почему многие антибиотики сегодня не в состоянии победить серьезные заболевания? Бактерии, и другие вредоносные микроорганизмы используют защитные механизмы, чтобы избежать гибели.

Когда с наступлением ноября погода начинает меняться всё чаще — от тёплых осенних дней до прохладных утр с утренними заморозками — организм подвергается дополнительной нагрузке.

Что кроется за распространенным и привычным диагнозом "вегетососудистая дистония"? Почему врачи привыкли в непонятных случаях, при общих, неопределенных симптомах ставить пациенту именно ВСД?

Когда лёгкие поражены воспалением, организм тратит на восстановление огромное количество ресурсов. В этом состоянии особенно заметно, насколько важны энергия, витамины и качественный белок — те самые элементы, которые помогают организму чинить повреждённые ткани и бороться с инфекцией.

Нельзя излечить отдельную вену, но можно улучшить состояние всей венозной системы натуральными средствами.

С течением времени меняется не только тело, но и наш мозг — орган, которому мы доверяем решения, память, творчество и ясность мысли. И хотя возрастные изменения неизбежны, они вовсе не означают, что мы обречены на автоматическое снижение когнитивных способностей.

Бактерии — и легкие, и более серьёзные возбудители инфекций — издавна лечили не только аптечными средствами, но и дарами природы. Пряности, корнеплоды, мёд и лечебные травы веками использовались как поддержка при воспалениях и простудах; это опыт, проверенный временем и переданный из поколения в поколение.

Когда сердце начинает работать «не по нотам» — перебои, замирания или хаотичное сердцебиение — многие из нас первым делом думают о кардиологии, консультации врача-кардиолога, медикаментах. Однако, стоит задуматься: возможно, именно нервная система является ключом к восстановлению нормального ритма.

Отказ от ежедневного кофе - это мужественный и решительный шаг. Естественно, организм, привыкший к кофеину, отреагирует определенным образом на отсутствие необходимых ему веществ. Как он справится без стимуляторов?

Когда за окном промозгло и сыро, иммунитет становится главным защитником от простуд и вирусов. С каждым днем холодает, усиливается ветер, а с ним — риск воспалений дыхательных путей, кашля, боли в горле и насморка. В такие периоды особенно важно поддерживать организм изнутри, используя простые, доступные и при этом действенные средства.

Когда мозг работает на пределе, а стресс, усталость и тревога мешают думать ясно — организму требуется подпитка. Не энергетиками и не бесконечными чашками кофе, а живыми веществами из растений, которые помогают восстановить внутренний баланс, поддерживают нейронную активность и возвращают ощущение ясности.

Если вы страдаете лишним весом и другими проблемами со здоровьем, вам обязательно нужно прочесть эту статью. Таких советов вам не дадут в больнице, поскольку большинство врачей лечат только симптомы заболевания, а не ищут истинную причину его развития.

Нас пугают экзотические болезни, или мы уверены, что по‑настоящему серьёзные заболевания остались в прошлом и современная медицина справится практически со всем? Увы — многие угрозы по‑прежнему рядом и забирают больше людей, чем принято думать.

Осень, конец октября — время, когда организм всё чаще просит уюта, тепла и поддержки. Пока многие спешат за витаминами в аптеку, природа по-прежнему предлагает свои простые и надёжные решения.

Если не заботиться о здоровье сейчас, проблемы с позвоночником, суставами и дёснами доставят массу страданий в будущем.

Поддерживать стройность тела сегодня — не просто вопрос внешнего вида, а необходимость для здоровья и долголетия. Избыточный вес не только снижает качество жизни, но и увеличивает риск развития диабета, сердечно-сосудистых и эндокринных заболеваний.

Наши предки говорили: «еда — лучшее лекарство». Эта пословица отражает важную практическую истину — многие пряности, давно вошедшие в повседневную кухню и народную медицину, обладают свойствами, которые поддерживают здоровье не только вкусовыми качествами, но и биологической активностью.

Осень дарит нам множество сезонных овощей и фруктов, привносит в нашу жизнь больше тепла, горячего какао и семейных вечеров с просмотром любимых фильмов. Но вместе с тем в эту пору года изменяются биологические ритмы. Узнайте, какие изменения происходят в организме осенью.

Мы живем в эпоху, когда информации вокруг больше, чем когда-либо, — но далеко не вся она заслуживает доверия. Многое, что мы привыкли считать истиной о собственном теле, на деле оказалось просто удобными мифами.

Заземление эффективно снимает воспаление, потому что оно разжижает кровь и насыщает вас отрицательно заряженными ионами через подошвы ног. Когда вы заземлены, отрицательно заряженные электроны, которые вы получаете, укрепляют структуру воды в клетках.

Осенью, когда дни становятся короче, а стресс накапливается, особенно важно поддерживать ясность ума и хорошее самочувствие. Мозг — не просто орган, отвечающий за память или мышление, это центр управления всем организмом: от дыхания до эмоций.

Каждый раз, когда мы доверяем нашему здоровью — выбираем лекарство, принимаем его, храним его — мы доверяем не только назначению врача, но и тому, что препарат соответствует тем стандартам, которые заложены в его маркировке, упаковке и составе.













Присоединяйтесь к нам в социальных сетях